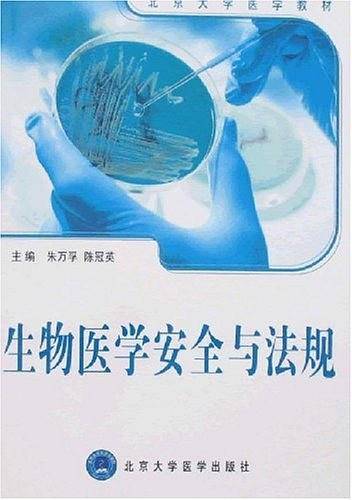
生物医学安全与法规

漫游鲸二手书店
淘二手好书+回收闲置图书

生物医学材料
李玉宝 | 化学工业出版社
ISBN:9787502547370
原价: ¥44.00
销售价:¥23.63元
参与书籍回收后,可享更低价格
分类
作者
李玉宝
出版社
化学工业出版社
图书简介
生物医学材料是一类与生物系统相互作用,用以评价、诊断、治疗、修复和替代人体病变或损伤的组织和器官以及增进其功能的材料。《生物医学材料》共分九章,分别从药物控制译放材料、纳米生物医学材料、生物活性材料、组织工程材料、介入诊断和治疗材料,可降解和吸收生物材料,整形美容外科生物材料等方面,对新型和新概念生物医学材料及其与生物体的相互作用进行了详细介绍。填补了国内该领域图书的空白。《生物医学材料》由从事医学材料研究多年的专家编写,实用性、先进性强,对增进人们对生物医学材料领域相关知识和发展动态的了解大有益处。《生物医学材料》可供从事生物医学方面的技术人员,研究人员使用,也可供各大医院的医生、研究人员及检验人员使用。
阅读更多
相关推荐
更多低价好书购买/书籍回收
扫码访问微信小程序